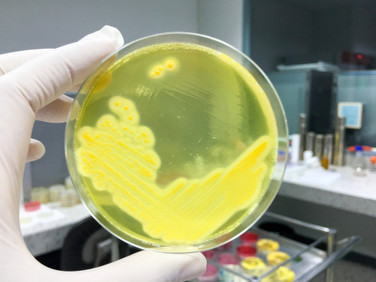

You'll receive the latest updates on new standards, guidelines, and educational resources, as well as expert insights to help enhance your laboratory's performance and compliance.
The Cefazolin Inoculum Effect for MSSA
Written By: William R. Miller and Cesar A. Arias
UTHealth McGovern Medical School, Houston, TX
Infections due to methicillin-sensitive Staphylococcus aureus (MSSA) continue to be a significant source of morbidity and mortality.1 While antistaphylococcal penicillins, such as nafcillin, have been the mainstay of therapy for MSSA, the use of cefazolin has grown increasingly popular. Indeed, recent data from observational clinical studies suggest that cefazolin is as efficacious as nafcillin, with less toxicity, has a more favorable dosing schedule, and possibly improves survival.2 Thus, cefazolin has become first line therapy for the treatment of MSSA infections.
Failures of cefazolin for deep-seated MSSA infections (ie, endocarditis) are well documented and have been associated with the activity of certain types of the staphylococcal β-lactamase.3-5 This enzyme, encoded by the blaZ gene, was originally divided into four isotypes (A, B, C, and D) based on serological assays, and now defined by amino acid sequence.6 Clinical failures of cefazolin occur most frequently with enzyme types A and C and have been linked to the cefazolin inoculum effect (CIE). This phenomenon is the loss of therapeutic efficacy of cefazolin and other early generation cephalosporin antibiotics when large numbers of organisms are present.7 In vitro, strains exhibiting the CIE may show minimum inhibitory concentrations (MICs) in the susceptible range at a standard inoculum of ~5x105CFU/mL. At a high inoculum of 5x107 or greater, such strains have a pronounced increase in the MIC of cefazolin to >16 µg/mL. This effect is abolished if BlaZ is absent or functionally inactivated by a β-lactamase inhibitor.8,9
The clinical impact of the CIE is an area of active study. In a 2017 narrative review of the published literature regarding the safety and efficacy of cefazolin versus anti-staphylococcal penicillins in MSSA bacteremia, Loubet and colleagues concluded that no significant differences in mortality or relapse rates between the two therapies were evident, although they advised caution due to the limitations of the available studies.10 Two studies published subsequently suggest that the presence of the CIE may have an impact on clinical outcomes for MSSA bacteremia with the use of cephalosporins as first-line therapy. A recent prospective observational study of 77 patients treated for MSSA bacteremia in Argentina (where antistaphylococcal penicillins are not available)11 showed a high prevalence of the CIE in MSSA (54.5%). This effect was associated with an increase in 30-day all-cause mortality (Risk ratio [RR] 2.65; 95% confidence interval [CI] 1.1-6.42) in patients with CIE-positive MSSA as compared to patients with MSSA lacking the CIE. Similarly, a study from Korea comparing nafcillin to cefazolin12 showed that ca. 22% of patients had isolates positive for the CIE. Most importantly, those patients infected with isolates that exhibited the CIE and treated with cefazolin were more likely to experience treatment failure (61.5% vs 28.9%; p=0.049) and death at one month (15.4% vs. 0%; p=0.047), as compared to patients with CIE-negative isolates. No difference in either outcome was noted with the nafcillin treatment group, regardless of the presence of the inoculum effect, suggesting that there were no differences in virulence between isolates from the two groups.
Currently, the only way to detect the CIE is by standard MIC determination at high bacterial inoculum. This test is both time consuming and cumbersome to perform, limiting its utility in the clinical microbiology lab. In addition, high inoculum MICs have not been evaluated and standardized by the CLSI, and we would discourage use of this technique outside of a research laboratory setting. It is also important to note that β-lactamase testing as described in the M100 document is for identification of staphylococci which are penicillin-resistant due to production of the BlaZ β-lactamase.13 This test cannot determine the presence or absence of the CIE and must not be used as a surrogate marker. The rapid identification of MSSA isolates exhibiting the CIE effect would permit clinicians to stratify patients at risk of cefazolin treatment failure and adjust therapy accordingly. CIE testing has the potential to improve patient outcomes in serious MSSA infections, in addition to cost savings and prevention of relapses.
In summary, MSSA producing staphylococcal β-lactamase that exhibit the CIE may contribute to treatment failure with cefazolin. Emerging data are conflicting, but some suggest that the CIE may have a direct clinical impact on patient mortality. The CIE is not currently detected by routine laboratory testing, and requests for testing of clinical isolates should be deferred until a standardized testing methodology becomes available. Ongoing efforts to develop rapid diagnostics are needed.
References:
1 Tong SYC, Davis JS, Eichenberger E, Holland TL, Fowler VG. Staphylococcus aureus infections: Epidemiology, pathophysiology, clinical manifestations, and management. Clin Microbiol Rev. 2015;28(3):603-661.
2 McDanel JS, Roghmann MC, Perencevich EN, et al. Comparative effectiveness of cefazolin versus nafcillin or oxacillin for treatment of methicillin-susceptible Staphylococcus aureus infections complicated by bacteremia: a nationwide cohort study. Clin Infect Dis. 2017;65(1):100-106.
3 Bryant RE, Alford RH. Unsuccessful treatment of staphylococcal endocarditis with cefazolin. JAMA. 1977;237(6):569-570.
4 Kaye D, Hewitt W, Remington J, Turck M. Cefazolin and Staphylococcus aureus endocarditis. JAMA. 1977;237(24):2601.
5 Nannini EC, Singh K V, Murray BE. Relapse of type A beta-lactamase-producing Staphylococcus aureus native valve endocarditis during cefazolin therapy: revisiting the issue. Clin Infect Dis. 2003;37(9):1194-1198.
6 Richmond MH. Wild-type variants of exopenicillinase from Staphylococcus aureus. Biochem J. 1965;94:584-593.
7 Nannini EC, Stryjewski ME, Singh KV, et al. Inoculum effect with cefazolin among clinical isolates of methicillin-susceptible Staphylococcus aureus: Frequency and possible cause of cefazolin treatment failure. Antimicrob Agents Chemother. 2009;53(8):3437-3441.
8 Nannini EC, Singh KV, Arias CA, Murray BE. In vivo effects of cefazolin, daptomycin, and nafcillin in experimental endocarditis with a methicillin-susceptible Staphylococcus aureus strain showing an inoculum effect against cefazolin. Antimicrob Agents Chemother. 2013;57(9):4276-4281.
9 Miller WR, Singh KV, Arias CA, Murray BE. Adjunctive clavulanic acid abolishes the cefazolin inoculum effect in an experimental rat model of methicillin-sensitive Staphylococcus aureus endocarditis. Antimicrob Agents Chemother. 2018;62(11):e01158-18
10 Loubet P, Burdet C, Vindrios W, et al. Cefazolin versus anti-staphylococcal penicillins for treatment of methicillin-susceptible Staphylococcus aureus bacteraemia: a narrative review. Clin Microbiol Infect. 2018;24(2):171-174.
11 Miller WR, Seas C, Carvajal LP, et al. The cefazolin inoculum effect is associated with increased mortality in methicillinsusceptible Staphylococcus aureus bacteremia. Open Forum Infect Dis. 2018;5(6)ofy123.
12 Lee S, Song K, Jung S, et al. Comparative outcomes of cefazolin versus nafcillin for methicillin-susceptible Staphylococcus aureus bacteraemia: a prospective multicentre cohort study in Korea. Clin Microbiol Infect. 2018;24(2):152-158.
13 CLSI. Performance Standards for Antimicrobial Susceptibility Testing. 27th ed. CLSI supplement M100. Clinical and Laboratory Standards Institute; 2017.
This article came from AST News Update, Volume 4, Issue 1 – January 2019 which is produced by the CLSI Outreach Working Group (ORWG). The ORWG is part of the CLSI Subcommittee on Antimicrobial Susceptibility Testing (AST) and was established in 2015. The formation of the working group originated in a desire to efficiently convey information regarding contemporary AST practices, recommendations, and resources to the clinical microbiology community. They welcome suggestions from you about any aspect of CLSI documents, educational materials, or their Newsletters.
For more articles and issues of the AST News Update, click here.